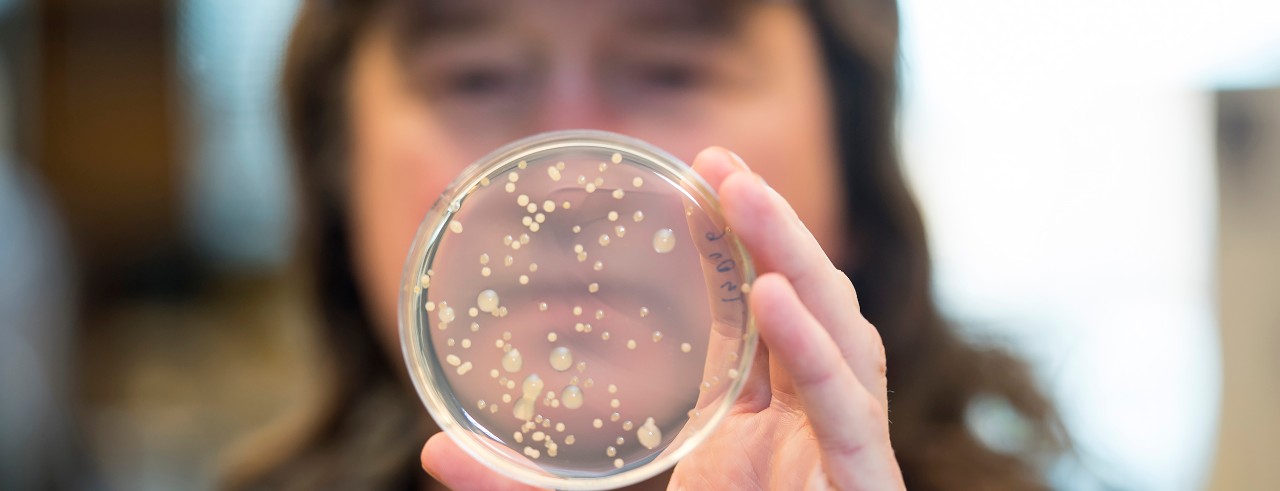
a scientist holds up a specimen dish in a lab

UC research shows effectiveness of ointment that kills antibiotic-resistant bacteria
Study shows topical drug promotes wound healing in a variety of burn injuries
Research from the University of Cincinnati College of Medicine shows that use of a topical drug, called AB569, a combination of acidified nitrite and EDTA (or ethylenediaminetetraacetic acid) promotes killing of antibiotic-resistant bacteria while enhancing the healing of wounds in a variety of burn injuries. The study was published in the journal Infection and Immunity.
AB569 was patented in the United States in 2018 by Daniel Hassett, PhD, professor in the Department of Molecular Genetics, Biochemistry and Microbiology at the UC College of Medicine. Hassett’s research has found that AB569 kills virtually all pathogenic bacteria tested with no observed acquired resistance. These, including multidrug resistant Pseudomonas aeruginosa (MDR-PA), are some of the most serious pathogens according to the Centers for Disease Control and Prevention exhibiting multidrug resistance and enhanced virulence properties.

Daniel Hassett, PhD, professor in the Department of Molecular Genetics, Biochemistry and Microbiology at the UC College of Medicine/Photo/Colleen Kelley/UC Creative + Brand
“Multidrug resistant bacteria, often called ‘superbugs,’ are an ever-burgeoning global health problem,” says Hassett. “As a result, there is a critical need to develop novel and effective antimicrobials for the prevention, treatment and eradication and healing of such wounds that are complicated by the most formidable pathogen of burn patients, known as MDR-PA. Injury severity is predominantly due to potentially lethal sepsis caused by MDR-PA.”
Hassett, who is the co-corresponding author on this study with Latha Satish, PhD, director of clinical lab operations at Cincinnati Children’s Hospital Medical Center, says the research shows AB569 acts synergistically to kill all human burn wound strains of the pathogen in vitro.
“AB569 not only kills the bug, it also enhances the wound-healing process,” says Hassett. “At the same time, AB569 topical application significantly increases the anti-inflammatory mediators...that allow improved epidermal restoration and the healing process to occur more rapidly and efficiently.”
AB569 was initially seen as a potential treatment for many antibiotic-resistant organisms that cause pulmonary infections in patients with cystic fibrosis and chronic obstructive pulmonary disease (COPD) and many other opportunistic infections. In addition to tackling COPD and cystic fibrosis, AB569 may also be effective in addressing infections related to severe burns, urinary tract disorders, endocarditis and diabetes, said Hassett.
“This study provides solid foundational evidence that AB569 can be used topically to treat highly problematic dermal [injuries] including wound, burn, blast and likely diabetic infections in civilian and military populations and help relieve the economical burden that MDR organisms have on the global health care system,” says Hassett.
Disclosures: Hassett is a stockholder and principal scientist at Arch Biopartners. AB569 is currently in a Phase 1 human trial at the Cincinnati VA Medical Center in healthy volunteers testing its safety and pharmacokinetic profile. AB569 has been licensed by the University of Cincinnati exclusively to Arch Biopartners, a Toronto-based publicly traded biotechnology company.
Lead photo of Daniel Hassett/Colleen Kelley/UC Creative + Brand
Next Lives Here
The University of Cincinnati is classified as a Research 1 institution by the Carnegie Commission and is ranked in the National Science Foundation's Top-35 public research universities. UC's medical, graduate and undergraduate students and faculty investigate problems and innovate solutions with real-world impact. Next Lives Here.
Related Stories
‘Designer drug’ shows early neuroprotective signal in acute ischemic stroke
October 28, 2025
Medscape highlighted new trial results led by the University of Cincinnati's Eva Mistry that found an experimental drug shows promise in protecting injured brain cells for patients with acute ischemic stroke.
Meet the young talent reshaping Cincinnati’s startup scene
October 28, 2025
Five University of Cincinnati students were honored for their impactful entrepreneurship on the Cincy Inno Under 25 list. We’ll explain what makes each student – and their startup – stand out.
Is menstrual fluid ‘the most overlooked opportunity’ in women’s health?
October 27, 2025
The Guardian recently reported that period blood has long been thought of as ‘stinky and useless’, but startups are exploring using the fluid to test for a wide range of health conditions — including endometriosis.
